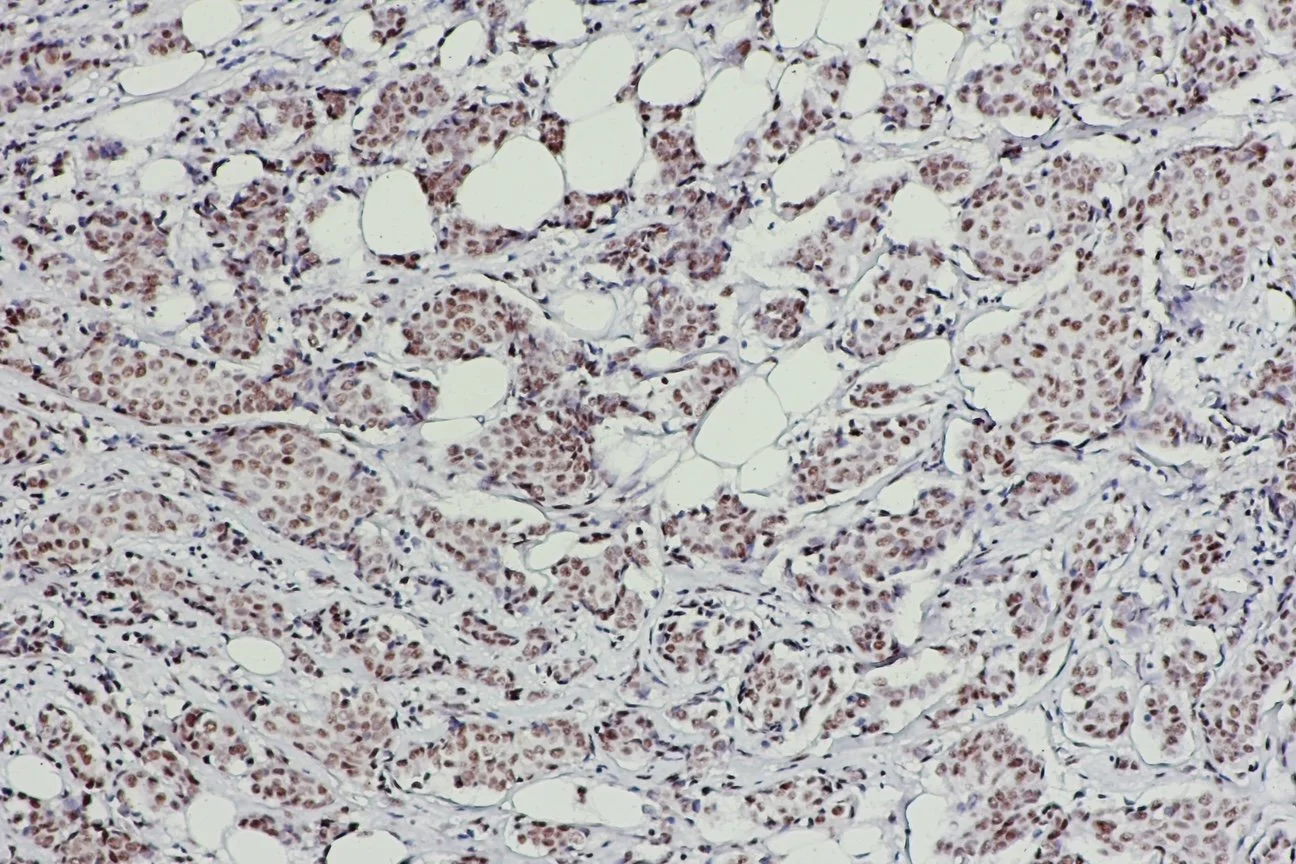

HIGH DENSITY

TISSUE MICROARRAYS AND WHOLE TISSUE SECTIONS
To meet the needs of target characterization for high-throughput sample analysis, Red Cube has acquired superior Tissue MicroArray technology which enables the systematic imprinting of tissue specimens on microscope slides.
Our Tissue MicroArray slides provide the capability to perform rapid analysis of comprehensive panels of normal and disease specimens. Also, for follow-on research, you have the option to access the source tissues for further studies such as whole sections.
HIGH DENSITY / MULTICOMPLEX TISSUE MICROARRAY SETS
Our high-density tissue microarray slides include up to 100 individual samples, double-spotted, representing broad surveys of specific diseases. Our high-density tissue microarrays are provided as sets of four unstained and one H&E slide, unless otherwise indicated.
Note: We also include a set of TE30 test slides to allow you to optimize antibody staining conditions prior to use of your high-density TMA slides.

-

HD00 NORMAL SCREENING SURVEY (5 unstained slides)
Over 200 individual samples, histologically defined Normal by Pathologist review. A survey of human anatomic sites.
-

HD00-2 NORMAL SCREENING SURVEY (3 unstained slides)
Same as HD00,
provided as a smaller slide set
-

HDCS CANCER SCREENING SURVEY (5 unstained slides)
Over 200 histologically defined carcinomas by Pathologist-reviewed.
Includes Breast, lung, colon, prostate, kidney, ovarian, head/neck, skin, liver, with matched adjacent normal
-

HDCS-2 CANCER SCREENING SURVEY (2 unstained slides)
Same as HDCS,
provided as a smaller slide set.
-

HD04 BREAST CANCER SURVEY (4 unstained slides)
Over 200 histologically defined carcinomas by Pathologist review,
Representing virtually all stages of breast cancer, from DCIS through Stage IV, Includes matched normals , benign disease (eg fibrocystic disease), and Clinically-defined normals. goes here
-

HD04- BREAST CANCER SURVEY (2 unstained slides)
Same as HD04,
provided as a smaller slide set.
-

HD60 COLORECTAL CANCER SURVEY (4 unstained slides)
Over 200 histologically defined carcinomas by Pathologist review, Representing all Duke’s Stages, A through D, benign conditions Including diverticulitis, IBD and clinically defined normals.
-

HD28 LUNG CANCER SURVEY (4 unstained slides)
Over 200 histologically defined carcinomas by Pathologist review, Representing most stages and histologically distinct forms of lung
Cancer, including SCLC, non-SCLC, squamous cell carcinoma, adenocarcinoma, with matched normals.
-

HD77 PROSTATE CANCER SURVEY (4 unstained slides)
Over 200 histologically defined carcinomas by Pathologist review, Representing all Gleason Grades, BPH, prostatitis, with Matched normals.
-

HD77-2 PROSTATE CANCER SURVEY (2 unstained slides)
Same as HD77,
provided as a smaller slide set.
Our proprietary microarray section transfer technology assures a >95% transfer efficiency. Normal tissue Control sections are included on all slides.
Our tissue microarrays are useful in the validation of new gene, protein, and antibody targets. With the matched follow-up and outcome data, a researcher can organize and analyze results in a statistically significant manner.

